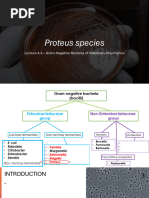

0% found this document useful (0 votes)
2K views6 pagesTshwane University of Technology
The document discusses the mechanisms by which Trypanosoma brucei, a protozoan responsible for sleeping sickness, survives and proliferates within the Tsetse fly, its vector host. It highlights the complex interactions between the parasite and the fly's immune system, including the parasite's ability to evade immune responses and adapt to the fly's environment. The study emphasizes the importance of various biotic and abiotic factors in the lifecycle of Trypanosoma and the challenges it faces in colonizing the Tsetse fly's midgut and salivary glands.
Uploaded by
qthulile32Copyright
© © All Rights Reserved
We take content rights seriously. If you suspect this is your content, claim it here.
Available Formats
Download as PDF, TXT or read online on Scribd
0% found this document useful (0 votes)
2K views6 pagesTshwane University of Technology
The document discusses the mechanisms by which Trypanosoma brucei, a protozoan responsible for sleeping sickness, survives and proliferates within the Tsetse fly, its vector host. It highlights the complex interactions between the parasite and the fly's immune system, including the parasite's ability to evade immune responses and adapt to the fly's environment. The study emphasizes the importance of various biotic and abiotic factors in the lifecycle of Trypanosoma and the challenges it faces in colonizing the Tsetse fly's midgut and salivary glands.
Uploaded by
qthulile32Copyright
© © All Rights Reserved
We take content rights seriously. If you suspect this is your content, claim it here.
Available Formats
Download as PDF, TXT or read online on Scribd
/ 6